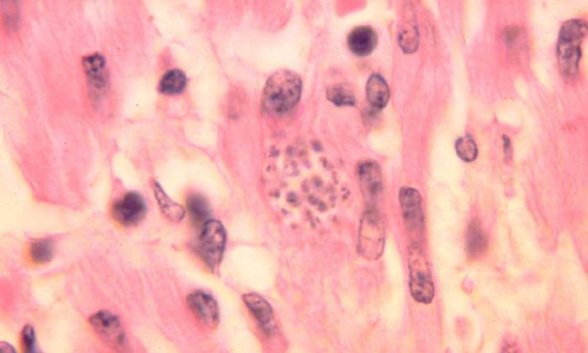

Enfermedad de Chagas transmitido por la «Chinche besucona», provoca afecciones en el corazón y neuronas. Se asocia a falta de piso firme y pobreza

Regeneración, 11 de octubre del 2019. Enfermedad de Chagas. Descubierta hace 110 años, se registra en 21 países de América Latina y causa 12 mil muertes al año en el mundo, afirmó Margarita Cabrera Bravo, de la Facultad de Medicina de la UNAM.
El portal de la Universidad Nacional Autónoma de México, indicó que se trata de una enfermedad «silenciosa y asociada a la pobreza, provoca daño principalmente en el corazón y las neuronas».

Lo anterior lo indicó Paz María Salazar Schettino, de la Facultad de Medicina.
Es considerada la parasitosis más grande de América Latina, detalló Yurika Manuel Valencia, de la Secretaría de Salud
Enfermedad silenciosa
En México, más de un millón de personas padecen la enfermedad de Chagas, que afecta principalmente al corazón y las neuronas.

Es una afección silenciosa y desatendida, ligada a la pobreza y a las viviendas sin piso firme.
En nuestro país se registra en Veracruz, Oaxaca, Chiapas, Yucatán, Morelos y el Estado de México.

Actualmente afecta a 21 países de América Latina y en el mundo hay entre seis y siete millones de personas infectadas.
Así mismo, 100 millones están en riesgo y por su causa ocurren 12 mil muertes al año.

El parásito
La enfermedad es ocasionada por el parásito Trypanosoma cruzi, que llega al torrente sanguíneo mediante la picadura de la chinche besucona.
Misma que puede expresarse después de 10 o 20 años de ocurrida la picadura, y causa insuficiencia cardiaca.
Conferencia de prensa
A 110 años del descubrimiento de esta enfermedad la Facultad de Medicina convocó a rueda de prensa.
En el evento, Margarita Cabrera Bravo, coordinadora de Ciencias Básicas de dicha facultad, destacó que este padecimiento ocurre en 21 países de América Latina, con mayor frecuencia en Argentina, Brasil y México.

Corazón y neuronas
La información fue vertida en el auditorio Fernando Ocaranza, por Paz María Salazar Schettino, jefa del Departamento de Microbiología y Parasitología.
Schettino encabeza un grupo de trabajo con más de 50 años de labor en el área.
La doctora comentó que el parásito puede invadir cualquier célula de nuestro cuerpo, excepto el eritrocito (célula sanguínea) y agregó:
“Tiene predilección por dos tipos de células importantes: el músculo y la neurona”.
En el corazón el parásito destruye las neuronas del haz de His, una formación intracardiaca consistente en un fino cordón de naturaleza muscular que forma parte del sistema de conducción del corazón.
“Esto ocasiona alteraciones del ritmo cardiaco”, explicó.
Cuando afecta al músculo, llega a producir un adelgazamiento del ventrículo izquierdo, produciendo un aneurisma, y puede provocar la muerte.
Respecto a las manifestaciones clínicas, Salazar indicó que éstas son disnea (ahogo o dificultad para respirar), taquicardia y palpitaciones.
Para el tratamiento antiparasitario específico solamente existen dos fármacos, ambos con efectos tóxicos.

Cómo evitarlo
La universitaria recomendó controlar las chinches al interior de las casas mediante el mejoramiento de la vivienda (especialmente piso firme), educación para la salud y empleo de insecticidas.
Para las especies que viven fuera de las casas pueden usarse mosquiteros y mallas en puertas y ventanas, y tener control biológico.

Secretaría de Salud
En el evento estuvo presente Yurika Manuel Valencia, del Centro Nacional de Programas Preventivos y Control de Enfermedades, de la Secretaría de Salud.
Yurika señaló que a 110 años de su descubrimiento, la enfermedad de Chagas es considerada la parasitosis más grande de América Latina.

En el país se han identificado 39 especies vectores, y por lo menos 21 de ellas se han encontrado infectadas con el parásito Trypanosoma cruzi.
“Las condiciones de la vivienda en muchas áreas del país favorecen la presencia del transmisor y el riesgo de adquirir la enfermedad”.
Actualmente, explicó, la Secretaría de Salud tiene en marcha el Programa de Acción Específico para la Vigilancia, Prevención y Control de la Enfermedad de Chagas, que incluye una visión de control integrado.

Contempla dos tratamientos para eliminar al parásito y disminuir la probabilidad de desarrollar complicaciones crónicas.
Así como contribuir a la interrupción de la cadena de transmisión.
En los últimos seis años, la Secretaría de Salud ha otorgado el tratamiento a unos dos mil pacientes.

Mismos que representan el 41 por ciento del total de casos notificados en el mismo periodo, concluyó.











